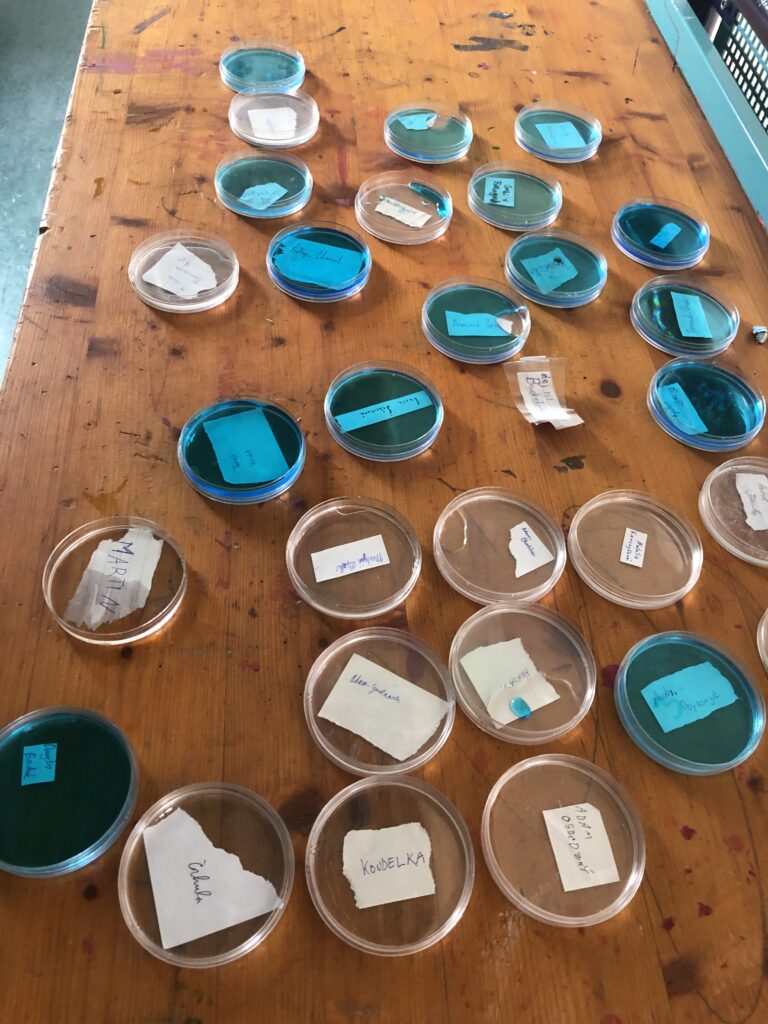
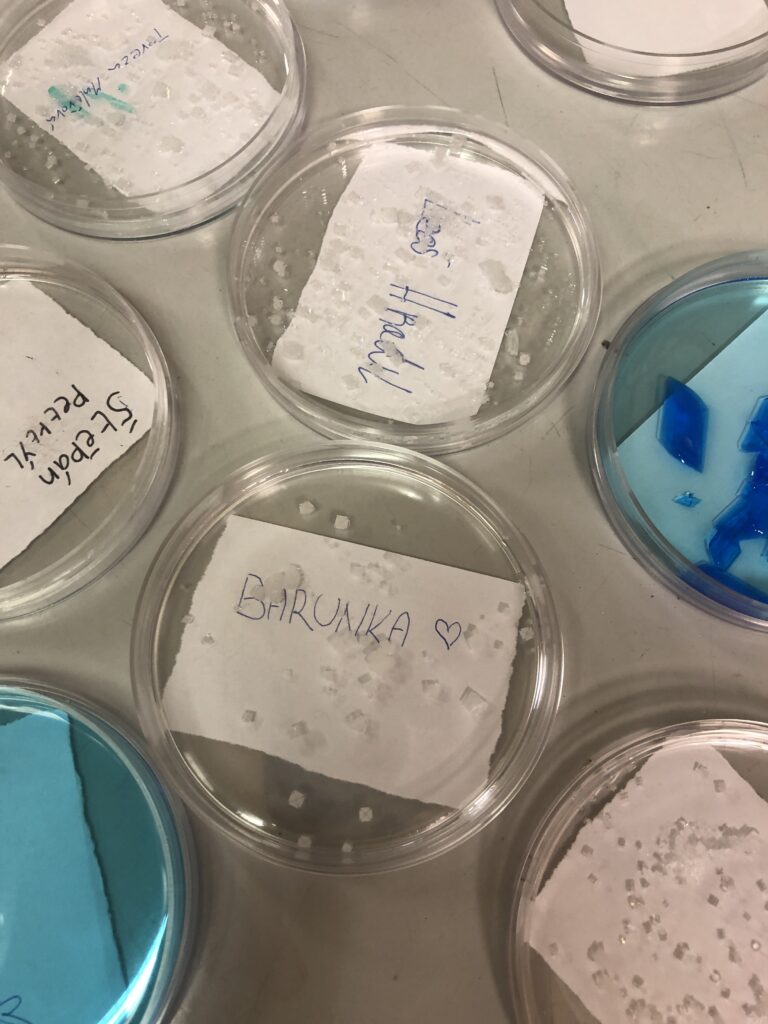
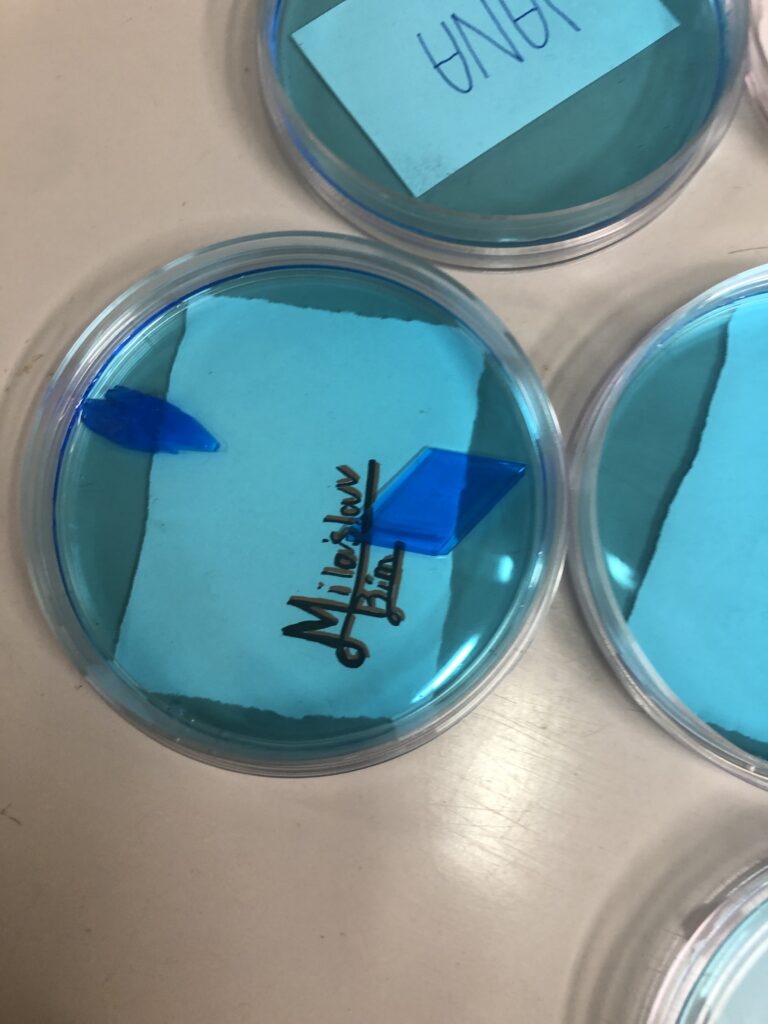

…. to je to, o co tu teď jde! Deváťáci si v rámci výuky PŘ vyzkoušeli namíchat ten správný roztok, aby se jim vytvořily co největší krystaly. Co se týče rychlosti, tak vítězové jsou v 9.C – tam se první krystalky objevily už druhý den. Velikostně ale vítězí 9.A. Tady si krystalizace dala na čas. Možná proto velikost krystalů byla ze všech největší – až 6 cm na délku. Co je ale důležité, krystaly se vytvořily úplně všem.